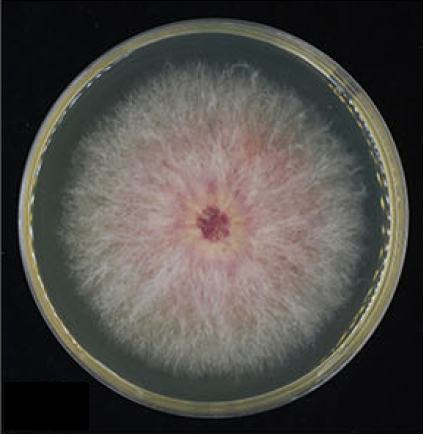

中国农业科学院博士后揭示小麦赤霉病致病新机制

感染了赤霉病的小麦
这种常发于小麦的病害被称为赤霉病(Fusarium head blight)。赤霉病不仅会严重降低小麦产量和籽粒品质,还会产生多种有毒真菌毒素,对人类和牲畜健康构成严重威胁。
从分子水平解析赤霉病的致病机制,对开发新型防控策略至关重要。
近日,中国农业科学院深圳农业基因组研究所(岭南现代农业科学与技术广东省实验室深圳分中心)张翠军课题组在《自然通讯(Nature Communications)》上发表题为“Fumarylacetoacetate hydrolase targeted by a Fusarium graminearum effector positively regulates wheat FHB resistance”的研究论文。该研究揭示了小麦赤霉病致病的新机制,首次证实了赤霉病主要致病菌——禾谷镰孢菌——通过效应蛋白定向破坏小麦代谢酶从而实现侵染的致病机理,为改良小麦赤霉病抗性和培育抗病品种提供了重要基因资源。
禾谷镰孢菌(Fusarium graminearum)是引起小麦赤霉病的主要病原真菌。
在初始侵染阶段,禾谷镰孢菌会像“微型降落伞”飘到植物表面,通过表面的黏附蛋白牢牢抓住小麦表皮,随后分泌水解酶、蛋白酶等“化学腐蚀剂”,溶解植物细胞壁的纤维素和果胶,进入植物内部后,禾谷镰孢菌会伪装成“膨胀菌丝”,初期菌丝像吹气球一样膨大,悄悄在细胞间蔓延,避免触发植物警报,后期大量产生DON毒素(呕吐毒素),毒死植物细胞,并利用死亡组织的营养疯狂繁殖,通过小麦穗轴入侵邻近小穗,最终让整株麦穗“全军覆没”。
禾谷镰孢菌
在病原菌侵染过程中,效应蛋白起着关键作用。
然而,禾谷镰孢菌编码数百种效应蛋白,哪个才是最“致命的”?
张翠军团队决心要找出“致病元凶”。
研究人员先是利用 SignalP 4.1 和 TargetP 2.0 预测分泌蛋白的信号肽(Signal Peptide, SP),筛选出148个候选效应蛋白,再结合禾谷镰刀菌侵染小麦期间的转录组数据,筛选出了感染阶段特异性高表达的前10个候选基因,对这10个基因逐一进行基因敲除后,发现敲,除FgEC10外,其他基因敲除后禾谷镰刀菌未表现出同等程度的致病力明显下降。
张翠军团队推测:FgEC10可能是禾谷镰孢菌致病的关键因子。
“伪装间谍”:FgEC10基因
为了验证这一猜想,研究人员开展了互补实验、分泌实验、免疫表型和互作蛋白筛选等一系列的实验,系统性地鉴定了FgEC10作为禾谷镰刀菌效应蛋白的关键角色,并揭示其通过靶向降解TaFAH抑制小麦免疫的分子机制。
张翠军团队形象地将这一过程总结为“四步走行动:伪装渗透-锁定目标-斩首行动-制造混乱”。
第一步:伪装渗透
研究发现,FgEC10的N端携带信号肽,能够能够伪装成“友好信使”,“骗”过防御系统,成功进入植物细胞内部。不仅如此,FgEC10的行事也极为“低调”,平时几乎不表达。一旦开始侵染,在早期阶段(24-48小时),FgEC10基因表达量会暴增60倍。此外,研究人员还发现,FgEC10的瞬时表达可显著抑制由flg22(细菌鞭毛蛋白)或几丁质(真菌细胞壁成分)诱导的活性氧(ROS)爆发和胼胝质沉积,这两种反应是植物免疫的重要核心警报机制。
第二步:锁定目标
下一步,FgEC10精准识别小麦的延胡索酰乙酰乙酸水解酶(TaFAH)。TaFAH是小麦免疫系统的“指挥官”,负责激活抗病基因(如MAPK、NBS-LRR)和积累抗菌氨基酸(如赖氨酸)。
第三步:斩首行动
有意思的是,FgEC10不直接破坏TaFAH,而是绑架小麦自身的26S蛋白酶体(类似细胞内的“垃圾处理厂”)。它通过增强TaFAH与蛋白酶体亚基TaPSMD12的结合,将TaFAH标记为“垃圾”加速降解,导致防御指令无法传达。
第四步:制造混乱
TaFAH降解后,小麦无法激活抗病基因(如MAPK信号通路、几丁质酶等),免疫反应被抑制,病菌趁机扩散,进一步瓦解代谢防线,最终实现禾谷镰孢菌的侵染。

“双效基因”:TaFAH基因
找到了致病元凶,该如何打赢这场“免疫之战”?
张翠军团队想,“如果提前让指挥官TaFAH‘扩编’,能不能抵抗FgEC10的进攻?”
研究人员在感病小麦品种Fielder中,通过转基因技术获得TaFAH过表达(OE)。接种禾谷镰刀菌后,TaFAH过表达株系表现出显著增强的抗病性(病指降低)、菌丝生物量和DON含量减少,更让研究人员感到惊喜的是,TaFAH还能促进小麦抽穗,与对照组相比,TaFAH过表达株系的抽穗期提前了约10天。
这一特性为培育抗病早熟小麦提供了新思路。
基因组所(大鹏湾实验室)张翠军研究员为论文通讯作者。基因组所(大鹏湾实验室)已出站博士后商圣平(现河南农业大学)为论文第一作者。
该研究得到中国农业科学院科技创新工程基础科学研究中心、国家自然科学基金及深圳市科学技术创新委员会等项目的支持。
原文链接:https://www.nature.com/articles/s41467-025-60736-y
